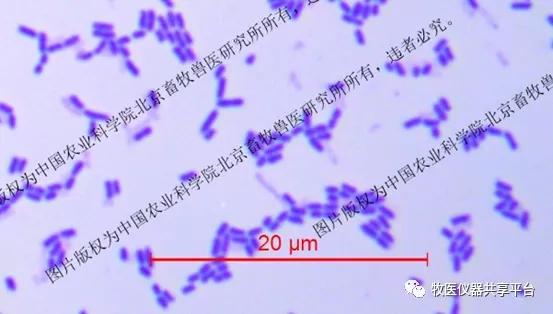

- 重磅!牧医所中心实验室建立宏基因组学微生物饲料添加剂菌种综合评价技术
- 饶正华 2020.05.25 903

全球每年消耗的抗生素总量90%用在食源动物身上,致使细菌耐药性和药物残留等问题日益突出。国家农业农村部已发布194号公告规定,自2020年元旦起,我国饲料中全面禁止添加抗生素,减少滥用抗生素造成的危害,维护动物源食品安全和公共卫生安全。
生物饲料具有促进动物健康、促进动物生长、提高饲料转化效率等功能,成为有效替代抗生素的重要手段。这使生物饲料产业发展迅猛,2019年仅前10个月,生物饲料的增长率就超过传统饲料的10倍,生产生物饲料的企业产量均为成倍增长,个别企业达到年产10万吨。
然而,市场的快速增长,也带来许多新的问题。产品的标识与实际包含的微生物是否一致?功能菌的纯度是多少?产品中是否含有致病菌?功能菌菌株的菌落形态、光学显微镜和扫描电镜下菌体形态是什么样的?菌株的是否含有耐药基因?是否含有毒力基因?菌种的基因组是什么?菌种的功能基因是什么?发酵性能如何?
种种的问题需要答案,新兴的市场需要完善。中国农业科学院北京畜牧兽医研究所中心实验室,以产业需求为抓手,着力开发畜牧行业新方法,通过3年的不懈努力,现推出畜牧功能微生物种质评估服务,主要内容如下:
1.畜产品中微生物多样性分析

图1 产品菌群
2.畜产品中微生物的分离与保藏

图2 自动化装置简化畜产品中微生物的分离与保藏
3.畜产品中微生物的形态学分析

图3 超大倍数观察使小型菌落更加清晰
图4 专业的标尺功能使革兰氏鉴定包含更多信息

图5扫描电镜使菌体表面的结构细节一览无余
4.畜产品中微生物的生化鉴定

图7畜产品中微生物的生化鉴定只需数小时
5.畜产品中微生物的耐药性分析

图8数十种抗生素耐药性快速分析
6.畜产品中微生物的基因组测序

图9基因组信息快速掌握
7.畜产品中微生物的耐药基因分析

图10畜产品中微生物耐药性的初步评估
8.畜产品中微生物的毒力基因分析

图11畜产品中微生物致病性的初步评估
9.畜产品中微生物发酵性能的评估


图12 通过豆粕发酵评估畜产品中微生物发酵性能
//推荐
暂无内容